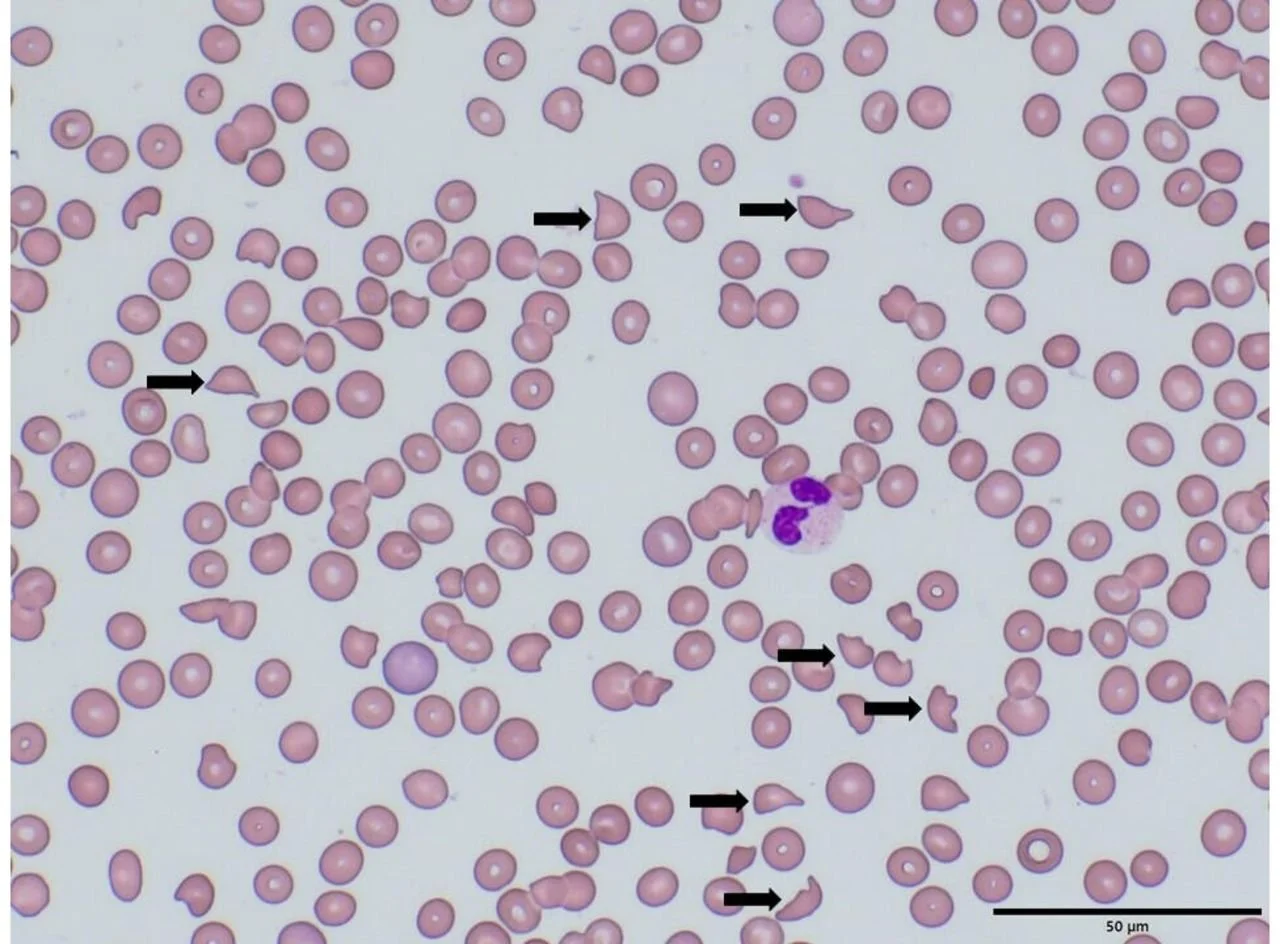

MAHA, TTP, HUS, DIC... Oh My! Understanding Microangiopathic Hemolytic Anemias
Enola Okonkwo, MD; Nicholas Lewis, BS; Claire Dalby, BA; Lorena Martinez, DO
INTRODUCTION
This blog post is going to focus on microangiopathic hemolytic anemias (MAHA) – namely, three major conditions characterized by microangiopathic hemolytic anemia: Thrombotic Thrombocytopenic Purpura (TTP), Hemolytic Uremic Syndrome (HUS), and Disseminated Intravascular Coagulation (DIC). These conditions should be added to the “Can’t Miss List” for Emergency Physicians. If you’re a medical student or physician who struggles to keep these conditions straight, you are not alone! However, understanding and recognizing these conditions may make the difference between life and death for a patient, further emphasizing the need to translate this word salad into clinical knowledge that can be applied in the ER.
Dr. Okonkwo recently gave a lecture focused on TTP, HUS, & DIC. Click the video to listen!
Thrombotic thrombocytopenic purpura (TTP), hemolytic uremic syndrome (HUS), and disseminated intravascular coagulation (DIC) fall under a larger class of pathologies known as thrombotic microangiopathies (TMAs). TMAs are broadly characterized by microthrombi formation that is secondary to endothelial damage (1). In TMAs, a clot forms and as the red blood cells pass by the clot, the cells are damaged and lysed, causing hemolysis. The hemolysis results in microangiopathic hemolytic anemia (MAHA).
TTP, HUS, and DIC have similarities, but their pathophysiology and management differ. It is critical to understand some of these differences so that patients receive prompt treatment.
Now let’s address the Top 3 on our Can’t Miss List:
1)TTP
2) HUS
3) DIC
Thrombotic thrombocytopenic purpura (TTP)
TTP is a rare condition that arises when a patient has insufficient levels of ADAMTS13 (either due to mutations or the development of antibodies), which is normally responsible for breaking down large multimers of von Willebrand factor (vWF). In the absence of ADAMTS13, these vWF multimers promote platelet adhesion (and eventual depletion) and subsequent thrombus formation, particularly in small vessels. The microthrombi can then shear and hemolyze passing red blood cells leading to microangiopathic hemolytic anemia (MAHA) and schistocyte formation.
“Basically, in TTP, ADAMTS13 is deficient and vWF chains get ridiculously long and platelets get entangled forming clots. These clots damage red blood cells as they pass by, resulting in hemolysis. This process causes both thrombocytopenia as platelets are entangled and anemia as red blood cells are lysed.”
Oftentimes, patients will present with TTP following a precipitating event, such as pregnancy, HIV, certain medications, or pancreatitis (2,3). Identifying and treating underlying conditions can be important in the initial assessment (4). When left untreated, TTP can lead to systemic microvascular thrombosis and thus cerebral, cardiovascular, and renal infarcts, with a mortality rate as high as 90% (5). With the appropriate use of early plasma exchange, this mortality rate is reduced to 10-20% of patients (5). From the perspective of an ER physician, the most important step in the treatment of TTP is to think about the condition and obtain early specialty consultation so that plasma exchange can be arranged without delay. Consultants may order additional treatments for TTP such as high dose steroids and Rituximab (4).
Hemolytic Uremic Syndrome (HUS)
In comparison, HUS most commonly occurs following exposure to the Shiga toxin (Stx); it is usually a result of O157:H7 enterohemorrhagic E. Coli (EHEC) infection (6,7). Stx then activates glomerular endothelial cells, leading to platelet adhesion, microthrombi formation, MAHA, and ultimately end-organ ischemia (8). HUS most commonly presents in pediatric patients, with greater than 90% of cases occurring in children < 5 years old. Atypical hemolytic uremic syndrome (aHUS) is a rare subtype of HUS that is complement-mediated and can present at any age (9). aHUS is also known as non-diarrheal hemolytic uremic syndrome, due to the absence of Stx, but in reality, patients may have diarrheal illness. Risk factors for aHUS include adult age, autoimmune disease, HIV, bacterial or viral illnesses, cancer, chemotherapy, pregnancy, preeclamspia/eclampsia, and genetic predispositions. Mortality rates for these conditions depend on their etiology, with pediatric cases of HUS demonstrating markedly lower rates of death or complications when compared to aHUS (upwards of 50% prior to the use of eculizumab for treatment) (9).
TTP and HUS are often taught using the mnemonic ‘FAT RN,’ a pentad used to demonstrate key manifestations of the conditions. The pentad is as follows:
**Disclaimer to our nursing friends, we don’t endorse the use of this mnemonic, but it is quite helpful.
Clinically, it is difficult to distinguish between HUS and TTP, especially in cases of aHUS presenting in adults. While the mnemonic can be useful to get an initial understanding of how these diseases present, it doesn’t tell the whole story when differentiating between TTP and HUS. Certain components of the pentad are more commonly seen in TTP when compared to HUS, and vice versa. In particular, the rates of renal manifestations are much higher in HUS, and conversely, neurological symptoms are more often observed in TTP (1). Seen below is an example of the relative occurrences of these manifestations.
It’s also important to realize that patients rarely present with the entire pentad, they may only have a few of the features. Thus, providers should not exclude a diagnosis due to the patient’s presentation not strictly following the mnemonic. Since there is so much overlap between TTP and HUS, Emergency physicians should consult hematology for possible empiric plasma exchange until TTP can be ruled out given the high rate of mortality associated with missing this condition. In the emergency room, the treatment of HUS often requires blood pressure management and treating hyperkalemia as needed. Patients may require emergent dialysis. Eculizumab is an antibody treatment that may be used inpatient (10).
Disseminated Intravascular Coagulation (DIC)
DIC is the most common of the three conditions discussed in this article. DIC is a serious, life-threatening condition that is characterized by both abnormal bleeding and abnormal clotting. Clinically, these patients appear ill, often toxic, which is one characteristic that can be useful in differentiating DIC from the other conditions. In DIC, there is a systemic activation of the coagulation cascade which results in imbalances in pro and anti-coagulant factors. Clinically, the bleeding manifestations are more easily observed and often dominate (11). DIC falls under the broad category of thrombotic microangiopathies and may result in MAHA. The underlying cause of DIC is generally related to conditions such as sepsis, cancer, trauma, or other serious conditions. Approximately, 30-60% of patients admitted for sepsis have DIC (12). The mortality rate for DIC varies depending on the precipitating factor but is estimated around 45-78% (12). Treatment in the ER should be focused on treating the underlying illness and providing supportive care. Blood products including packed red blood cells, platelets, fresh frozen plasma, and fibrinogen concentrate may be needed. In patients with predominant thrombosis, heparin may be required (11).
Work Up
What type of work up will help differentiate between these conditions?
While the presentation and history may help differentiate these conditions, the laboratory work up will be important to confirm the diagnosis and differentiate between entities. All of the conditions mentioned above have two major laboratory abnormalities in common: thrombocytopenia and anemia.
Since these conditions are characterized by anemia and thrombocytopenia, a CBC is essential. In the setting of a hemolytic anemia, several other lab abnormalities will be present such as increased LDH, increased reticulocyte count, decreased haptoglobin, increased indirect bilirubin, and a peripheral blood smear which should demonstrate the presence of schistocytes, which are fragmented RBCs formed through the shearing force against microthrombi. An example of schistocytes on a peripheral blood smear, a hallmark sign of MAHA, is seen below:
Image Source: Peripheral blood smear of a patient with microangiopathic haemolytic anemia with schistocytes in HUS (arrows). ResearchGate.
A hemolysis screen of a patient with a TMA will demonstrate reduced haptoglobin, increased LDH (with the degree of elevation directly correlating with the severity of the condition), a negative Coomb’s test, and unconjugated hyperbilirubinemia with urinary urobilinogen (3,8). An elevated creatinine could also be present in any of these conditions but will likely be a more salient feature in HUS.
There’s a great chart from The Internet Book of Critical Care below that helps to compare and contrast the thrombotic microangiopathies that can result in MAHA2.
ITP is often confused with these conditions but does NOT cause MAHA.
ITP, or Immune Thrombocytopenic Purpura, is an autoimmune condition that causes thrombocytopenia but does not result in hemolytic anemia. ITP is often confused with thrombotic microangiopathies, but it does not fall under the category of TMAs and DOES NOT cause MAHA! Patients with ITP may have signs of thrombocytopenia such as petechiae or bruising, or even more serious manifestations such as spontaneous intracerebral hemorrhage depending on the platelet level.
Management Pearls Summarized
TTP, HUS, and DIC are emergent, potentially life-threatening conditions, and should be treated as such. While the specific treatments for these conditions differ, supportive care is universal to all the conditions.
· Resuscitate the patient as needed and consider any precipitating factors (infection, cancer, HIV, pregnancy, etc.).
· Early consultations with intensivists, nephrologists, and hematologists are essential in facilitating the appropriate treatment and confirming the ultimate diagnosis.
· Avoid platelet transfusion in TTP and HUS, unless there are life-threatening clinical indications, such as intracranial hemorrhage (3,8).
· Packed red blood cell transfusions as needed for symptomatic anemia.
· The treatment of TTP is Plasmapheresis (plasma exchange). While the relative effectiveness of plasma therapy in treating HUS requires further investigation, it is still recommended to initiate this treatment empirically in any patient with high concern for TTP while awaiting definitive testing to differentiate between HUS and TTP.
· Consider antibiotics if an underlying infection is identified or there is high concern for sepsis. However, avoid antibiotics in HUS as this may worsen the condition. It is best to avoid antibiotics in bloody diarrhea.
Clinical Case from the TGH Case Files
A 67 y/o male with past medical history significant for prostate cancer s/p resection and radiation, and polycythemia vera presented to the emergency department with right lower quadrant abdominal pain, hematemesis, and blood in his stool for 1 day. On exam, his vitals were reported as pulse of 64, blood pressure of 153/92, and a temperature of 97.2. He was non-toxic appearing and alert and oriented. He had mild abdominal tenderness in the right lower quadrant and a small amount of blood was noted at the urethral meatus. The remainder of his physical exam was normal. His laboratory revealed multiple derangements as seen below. Most notably, he had acute kidney injury, transaminitis, and thrombocytopenia. Of note, with his history of polycythemia vera, he also had relative anemia.
The initial differential considered by the ED included appendicitis, gastrointestinal bleed, gastroenteritis. Following laboratory work up, this differential was expanded to include acute kidney injury, hepatitis, TTP, ITP, massive bleed, aortic pathology, DIC, and other systemic processes resulting in multiorgan failure such as sepsis. The patient underwent a non-contrast CT scan which showed possible pyelonephritis versus renal insufficiency and a completely collapsed bladder secondary to oliguric renal failure. He also underwent a right upper quadrant ultrasound which was remarkable for possible steatohepatitis. During his emergency department course he remained non-toxic. A foley catheter was placed and he received a small fluid bolus of normal saline. A peripheral blood smear and DIC labs were ordered, and the emergency department placed a consult to critical care, nephrology, and hematology. The peripheral blood smear returned positive for schistocytes, suggesting microangiopathic etiology.
Hematology started the patient on therapeutic plasma exchange (PLEX) for 2 days inpatient to treat for possible TTP. An ADAMTS13 lab was sent and returned on day 2 at a level of 62%. PLEX was discontinued. He was diagnosed with aHUS with secondary AKI requiring dialysis. He was treated with eculizumab on day 5. Ultimately, the patient survived, and his thrombocytopenia and anemia resolved, but he did require long-term dialysis.
Dr. Lorena Martinez (right), presented this case of aHUS at Symposium by the Sea in August 2022.
References
1) Bommer M, Wölfle-Guter M, Bohl S, Kuchenbauer F. The Differential Diagnosis and Treatment of Thrombotic Microangiopathies. Dtsch Arztebl Int. 2018 May 11;115(19):327-334.
2) Farkus, J. Thrombotic microangiopathies including TTP, ST-HUS, and C-HUS. The Internet Book of Critical Care. Thrombotic microangiopathies (including TTP, ST-HUS, and C-HUS) - EMCrit Project. Published May 6, 2021.
3) Nickson C. Thrombotic Thrombocytopenic Purpura. Life in the Fast Lane • LITFL. https://litfl.com/thrombocytopaenic-thrombotic-purpura-ttp/. Published November 3, 2020.
4) Blombery P, Scully M. Management of thrombotic thrombocytopenic purpura: current perspectives. J Blood Med. Feb 2014; 5:15-23.
5) George JN. Thrombotic Thrombocytopenic Purpura. New England Journal of Medicine. 2006;354(18)
6) Noris M, Remuzzi G. Hemolytic Uremic Syndrome. Journal of the American Society of Nephrology. 2005;16(4):1035-1050.
7) Ostroff SM, Kobayashi JM, Lewis JH. Infections with Escherichia coli O157:H7 in Washington State. The first year of statewide disease surveillance. JAMA 1989; 262: 355–9.
8) Nickson C. Haemolytic Uraemic Syndrome . Life in the Fast Lane • LITFL. https://litfl.com/haemolytic-uraemic-syndrome-hus/. Published November 3, 2020.
9) Kavanagh D, Goodship TH, Richards A. Atypical haemolytic uraemic syndrome. Br Med Bull. 2006;77-78:5-22.
10) Loirat C, Fakhouri F, Ariceta G, Besbas N, Bitzan M, Bjerre A, Coppo R, Emma F, Johnson S, Karpman D, Landau D, Langman CB, Lapeyraque AL, Licht C, Nester C, Pecoraro C, Riedl M, van de Kar NC, Van de Walle J, Vivarelli M, Frémeaux-Bacchi V; HUS International. An international consensus approach to the management of atypical hemolytic uremic syndrome in children. Pediatr Nephrol. 2016 Jan;31(1):15-39. doi: 10.1007/s00467-015-3076-8. Epub 2015 Apr 11. PMID: 25859752.
11) Tintinalli's Emergency Medicine Manual, 8e Eds. Rita K. Cydulka, et al. McGraw Hill, 2017, https://accessemergencymedicine.mhmedical.com/content.aspx?bookid=2158§ionid=162268406.
12) Singh B, Hanson AC, Alhurani R, et al.: Trends in the incidence and outcomes of disseminated intravascular coagulation in critically ill patients (2004-2010): a population-based study. Chest. 2013, 143:1235-42. 10.1378/chest.12-2112
About the Authors
Dr. Enola Okonkwo is the Associate Program Director at USF Emergency Medicine and the creator of the Tampa Emergency Medicine Blog. Nick Lewis and Claire Dalby are medical students at the University of South Florida Morsani College of Medicine. Dr. Lorena Martinez, in a senior resident at the University of South Florida Emergency Medicine residency program and the editor the Tampa Emergency Medicine Blog for the 2023-2024 year.